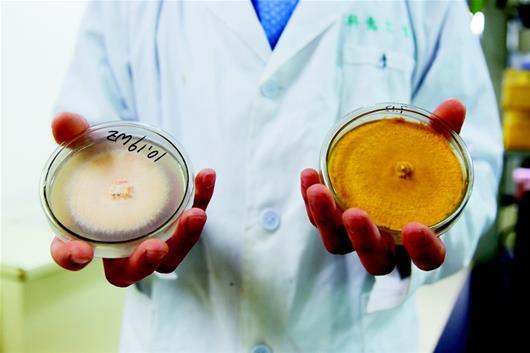

提到灵芝、牛樟芝、冬虫夏草等中药材,你的第一反应肯定是贵。华中农大生命科学技术学院教授梁运祥和他的团队,将大豆、玉米等粗粮做成培养基,把天然虫草菌、灵芝菌纯化后接种在上面,竟能低成本、大批量地生产出这些药材。前日,记者前往梁运祥药用菌实验室进行了探访。
药材活性物与野生相差无几
华农微生物农药国家工程研究中心的一间培养室里,竖着几个铁架,上面摆满了装着固态培养基的塑料袋。牛樟芝的菌丝体从培养基上冒出粉色的“小脑袋”,长势十分喜人。
梁运祥说,牛樟芝以往是台湾特有的真菌,因数量稀少、采集不易,市价高达每斤数十万新台币(约合人民币2万元),“牛樟芝、灵芝、虫草等都不是真正的植物,而是由真菌发育形成的子实体。运用微生物发酵技术,就可模拟原生态培养出这些名贵药材。”
记者还看到了人工培养的冬虫夏草。“冬虫夏草本来是虫草菌寄生在蝠蛾幼虫体内,吸取虫体内的营养发育而成,人工条件下很难模拟这个过程。”因为虫草的有效成分是虫子体内的菌丝,梁运祥用营养成分与虫体相当的大豆进行替代,添加配料后接种上菌丝,就能“种”出虫草。
梁运祥提供的数据显示,利用微生物发酵技术培养出的药材,活性物质与野生的相差无几。他的团队曾做过实验,将一组小鼠正常喂养,另一组饲喂人工灵芝。前者平均寿命20个月,后者为22个月。“换算成人的寿命,相当于多活了6到8年。”梁运祥说。
梁运祥团队副教授梅余霞还介绍,培养药用菌收获周期比野生的要短不少,“天然牛樟芝生长周期3个月,人工培养只需半个月。”
市民未来可吃到价格跳水的“神草”
记者在一家知名网购平台上看到:一瓶60粒的浓缩牛樟芝胶囊,900元左右;一种90粒装的灵芝孢子粉胶囊882元,每粒含量0.35克;四条共1克重的虫草200元。而实体店的价格更高,不少老百姓因此望而却步。
梁运祥教授算了这样一笔账,利用微生物发酵技术,这些“神草”的价格将会大跳水。如灵芝孢子粉的成本价每公斤200元,市场价预计每克0.5元;冬虫夏草的成本价大概每公斤500元,市场价预计每克1元。“微生物很神奇,我们就想利用它们生产出老百姓吃得起的高价保健品。”梁运祥说,华中农大药用菌团队耗费多年时间,摸索出了灵芝、虫草、牛樟芝、桑黄等多种药用菌的人工培育技术,正在申请国家批文,这些名贵药材可能不久后就会价格跳水,走进寻常百姓家。













